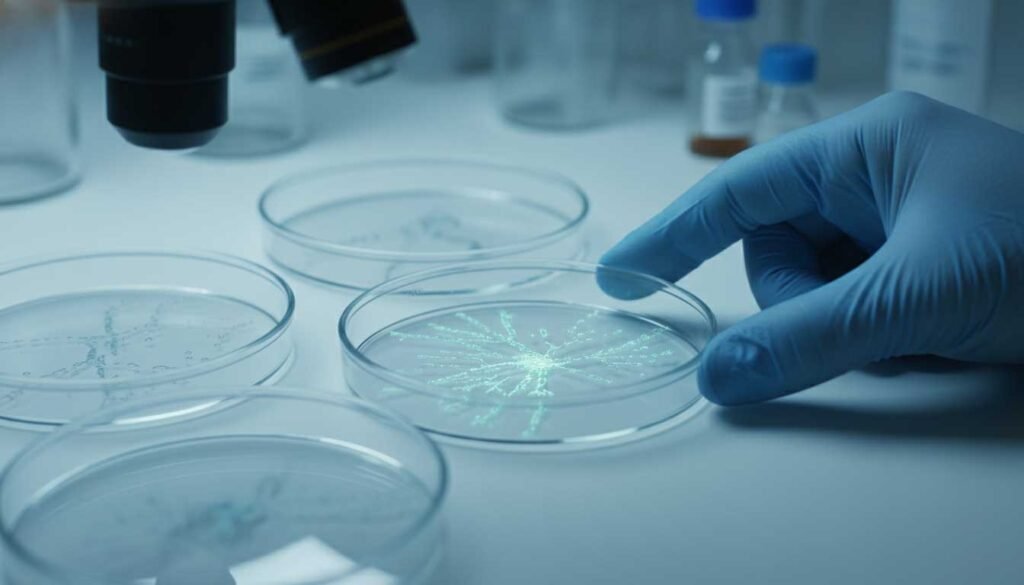

Le vrai changement commence quand tu arrêtes de te juger.

Le vrai changement commence quand tu arrêtes de te juger. Quand quelque chose ne va pas, fatigue persistante, sommeil irrégulier, manque d’énergie, difficultés à tenir un rythme; la réaction la plus courante est rarement neutre. On se parle durement.On se juge.On se résume à ses échecs. Je n’ai aucune discipline. Je suis nulle. Je n’y […]
Fêtes de fin d’année : alcool, excès alimentaires et fatigue — comprendre ce qui épuise vraiment le corps

Fêtes de fin d’année : alcool, excès alimentaires et fatigue — comprendre ce qui épuise vraiment le corps Fêtes de fin d’année : alcool, excès alimentaires et fatigue — comprendre ce qui épuise vraiment le corpsChaque fin d’année, le même scénario se répète.On parle de “gueule de bois”, de digestion compliquée, de fatigue persistante… comme […]
Vitamine D : le nutriment essentiel que tout le monde connaît… mais que presque personne ne comprend vraiment.
Il y a des nutriments qu’on croit connaître.La vitamine D en fait partie : “la vitamine du soleil”, celle qui soutient les os et l’immunité, mais ce que la science découvre ces dernières années dépasse largement son rôle “classique”. Immunité, énergie, cognition, santé cellulaire : ce micronutriment influence des fonctions bien plus vastes qu’on ne […]
Matin ou soir ? La science tranche sur le timing des nutriments.

Méta-description : La chronobiologie montre que le moment où l’on prend ses vitamines, minéraux et acides aminés influence leur efficacité. Voici comment et pourquoi le système 24 h ONE DAY / ONE NIGHT respecte ces rythmes biologiques. Pourquoi le moment de la prise compte autant que le nutriment : la chronobiologie appliquée à la micronutrition […]
Pourquoi les formules ‘tout-en-un’ ne fonctionnent pas comme on le croit ?

Les compléments alimentaires affichent parfois 40, 60 ou 90 ingrédients. Mais que dit la science sur l’absorption, le foie, les interactions et la chronobiologie ? Voici un décryptage factuel pour choisir une formule réellement efficace. Quand “plus d’ingrédients” ne veut pas dire meilleure formule : où se situe la vraie limite dans les compléments alimentaires […]
Pourquoi la plupart des compléments ne réduisent pas la fatigue ?

Pourquoi la plupart des compléments ne réduisent pas la fatigue ? “et si le vrai problème était… les mauvais produits ?” (Pourquoi une grande étude conclut que les compléments ne servent à rien et pourquoi nous sommes, en partie, d’accords.) Introduction Une étude suisse publiée en 2025* conclut que la prise de compléments alimentaires n’a […]
Boissons énergétiques : le « coup de fouet » qui vous épuise.

Boissons énergétiques : le « coup de fouet » qui vous épuise Et l’alternative saine pour viser une énergie plus stable, sans le « pic-crash ». Moins de pic, plus de fond : remplacer l’illusion d’énergie par une routine matinale plus propre. Pourquoi elles séduisent (et pourquoi ça coince) Journée dense et intense, on saisit […]
Passiflore, magnésium, reishi, tryptophane, … : la science derrière la formule NIGHT

Derrière chaque journée réussie, il y a une nuit qui a compté.Pas forcément longue, mais réparatrice, profonde, où le corps et l’esprit retrouvent leur équilibre.Pourtant, ce moment est devenu rare. Les nuits se fragmentent, les écrans prolongent l’éveil, les pensées tournent, et le sommeil devient un combat au lieu d’un refuge. C’est pour remettre de […]
Moins de fatigue, plus de clarté : comprendre la formule DAY

Ingrédients & Bienfaits de la Formule DAY Énergie, clarté mentale, protection cellulaire : un trio pour bien démarrer la journée On ne le répétera jamais assez : les journées d’aujourd’hui n’ont plus rien de “normales”.Elles commencent tôt, finissent tard, et laissent rarement le temps de souffler. Entre travail, responsabilités et pression permanente de performance, beaucoup […]
La révolution ONE – Une nouvelle vision du bien-être accessible à tous

Introduction : ONE, une marque qui redéfinit les compléments alimentaires Dans un marché saturé de promesses souvent exagérées, ONE se distingue en proposant une approche à la fois innovante et minimaliste. Avec seulement deux produits – Day Formula et Night Formula – la marque combine simplicité, efficacité, praticité et transparence. Inspirée par les principes de […]